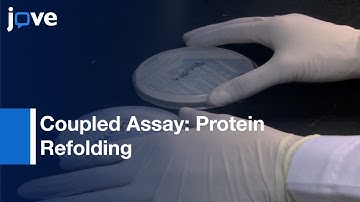
Monitoring Protein Refolding In Saccharomyces Cerevisiae:Coupled Assay

⬇ DOWNLOAD NOW
Jika muncul iklan pop-up, tutup lalu klik tombol kembali
Download lagu Microarray Analysis For Saccharomyces cerevisiae l Protocol Preview secara gratis hanya untuk keperluan promosi. Dukung artis favorit kamu dengan membeli musik original di iTunes atau platform resmi lainnya.
 Rapid Identification Of Chemical Genetic Interactions In Saccharomyces cerevisiae l Protocol Preview
Rapid Identification Of Chemical Genetic Interactions In Saccharomyces cerevisiae l Protocol Preview DNA Microarray (DNA chip) technique
DNA Microarray (DNA chip) technique Gene Expression Analysis and DNA Microarray Assays
Gene Expression Analysis and DNA Microarray Assays Dissection Of Saccharomyces Cerevisiae Asci l Protocol Preview
Dissection Of Saccharomyces Cerevisiae Asci l Protocol Preview Measurement Of mRNA Decay Rates In Saccharomyces cerevisiae l Protocol Preview
Measurement Of mRNA Decay Rates In Saccharomyces cerevisiae l Protocol Preview DNA Microarray Methodology
DNA Microarray Methodology Monitoring Protein Refolding In Saccharomyces Cerevisiae:Coupled Assay
Monitoring Protein Refolding In Saccharomyces Cerevisiae:Coupled Assay Microarray Lab
Microarray Lab